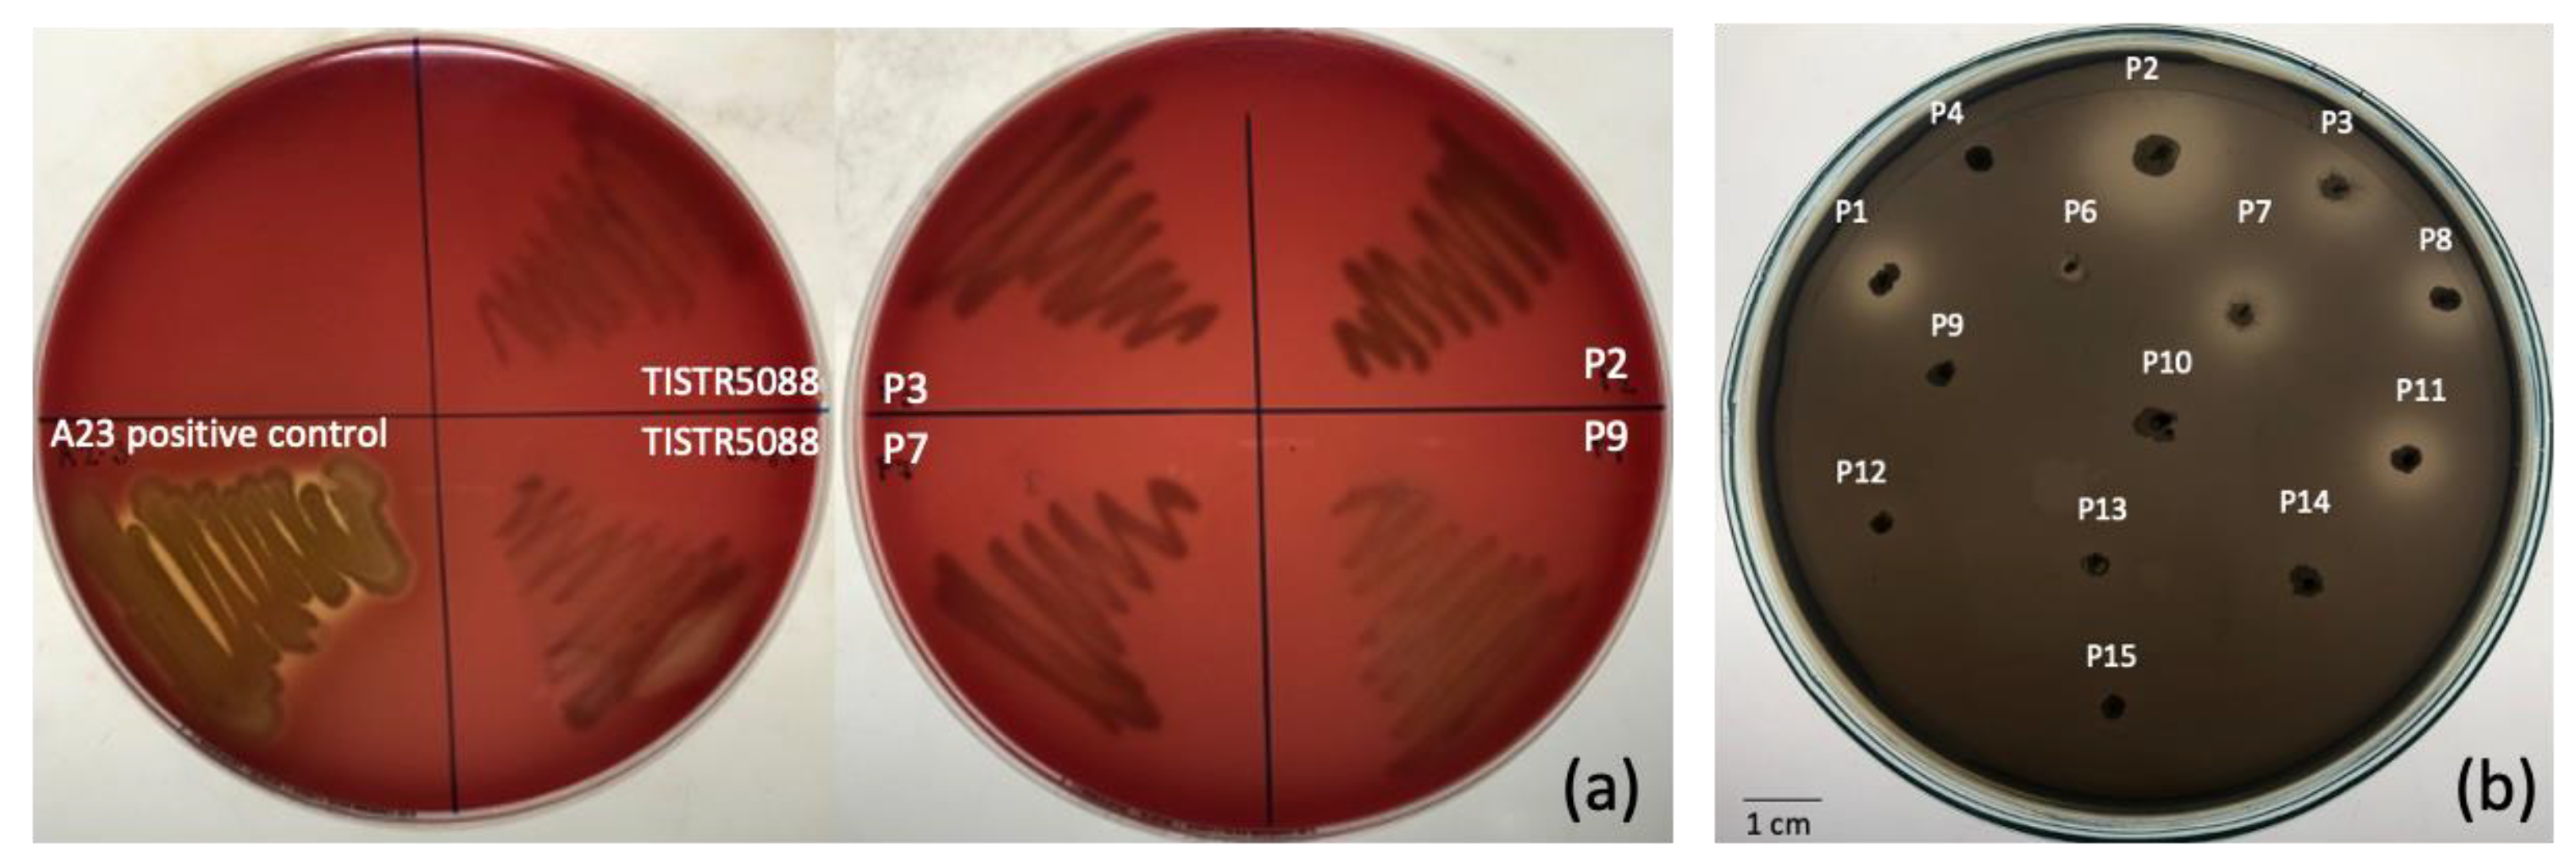
Jof 09 00165 g002 Jof 09 00165 g002

Assessment of Tannin Tolerant Non-Saccharomyces Yeasts Isolated from Miang for Production of Health-Targeted Beverage Using Miang Processing Byproducts
Abstract
1. Introduction
2. Materials and Methods
2.1. Strains, Media and Culture Conditions
2.2. Screening of the Yeasts for their Ethanol Producing Capability
2.3. Probiotic Characterization and Tannin-Tolerance Test
2.4. Molecular Identification and Carbon Assimilation Profiles
2.5. Analysis of the Volatile Compounds
2.6. MF (Miang Fermentation) Broth Fermentation
2.7. Enumeration of the Microbes and the pH Measurement
2.8. Analysis of Glucose, Ethanol, Organic Acids, Catechins and Caffeine by HPLC
2.9. Determination of the Bioactive Compounds
2.10. β-Glucosidase Activity Assay
2.11. Statistical Analysis
3. Results and Discussion
3.1. Screening of Yeast with Potential Characteristics
3.2. Molecular Identification and Carbon Assimilation Profiles
3.3. Yeast Growth Dynamic and pH Changes in MF (Miang Fermentation) Broth
3.4. Changes in the Sugar Consumption, Ethanol Production and Organic Acid Formation
3.5. Phenolic Compounds and Antioxidant Activity
3.6. β-Glucosidase Activity in MF-Broth Fermentation
3.7. Volatile Aromatic Compounds in MF-Broth Fermentation
4. Conclusions
Author Contributions
Funding
Institutional Review Board Statement
Informed Consent Statement
Data Availability Statement
Acknowledgments
Conflicts of Interest
References
- Khanongnuch, C.; Unban, K.; Kanpiengjai, A.; Saenjum, C. Recent research advances and ethno-botanical history of Miang, a traditional fermented tea (Camellia sinensis var. assamica) of northern Thailand. J. Ethn. Foods 2017, 4, 135–144. [Google Scholar] [CrossRef]
- Kanpiengjai, A.; Chui-Chai, N.; Chaikaew, S.; Khanongnuch, C. Distribution of tannin-'tolerant yeasts isolated from Miang, a traditional fermented tea leaf (Camellia sinensis var. assamica) in northern Thailand. Int. J. Food Microbiol. 2016, 238, 121–131. [Google Scholar] [CrossRef]
- Kodchasee, P.; Nain, K.; Abdullahi, A.D.; Unban, K.; Saenjum, C.; Shetty, K.; Khanongnuch, C. Microbial dynamics-linked properties and functional metabolites during Miang fermentation using the filamentous fungi growth-based process. Food Biosci. 2021, 41, 100998. [Google Scholar] [CrossRef]
- Unban, K.; Khatthongngam, N.; Shetty, K.; Khanongnuch, C. Nutritional biotransformation in traditional fermented tea (Miang) from north Thailand and its impact on antioxidant and antimicrobial activities. J. Food Sci. Technol. 2019, 56, 2687–2699. [Google Scholar] [CrossRef]
- Kanpiengjai, A.; Khanongnuch, C.; Lumyong, S.; Kummasook, A.; Kittibunchakul, S. Characterization of Sporidiobolus ruineniae A45. 2 Cultivated in Tannin substrate for use as a potential multifunctional probiotic yeast in aquaculture. J. Fungi 2020, 6, 378. [Google Scholar] [CrossRef] [PubMed]
- Sabel, A.; Martens, S.; Petri, A.; König, H.; Claus, H. Wickerhamomyces anomalus AS1: A new strain with potential to improve wine aroma. Ann. Microbiol. 2014, 64, 483–491. [Google Scholar] [CrossRef]
- Padilla, B.; Gil, J.V.; Manzanares, P. Challenges of the non-conventional yeast Wickerhamomyces anomalus in winemaking. Fermentation 2018, 4, 68. [Google Scholar] [CrossRef]
- Akyereko, Y.G.; Wireko-Manu, F.D.; Alemawor, F.; Adzanyo, M. Effects of production methods on flavour characteristics of nonalcoholic wine. J. Food Qual. 2021, 2021, 3014793. [Google Scholar] [CrossRef]
- Bellut, K.; Michel, M.; Zarnkow, M.; Hutzler, M.; Jacob, F.; Atzler, J.J.; Hoehnel, A.; Lynch, K.M.; Arendt, E.K. Screening and application of Cyberlindnera yeasts to produce a fruity, non-alcoholic beer. Fermentation 2019, 5, 103. [Google Scholar] [CrossRef]
- Lara-Hidalgo, C.; Hernández-Sánchez, H.; Hernández-Rodríguez, C.; Dorantes-Álvarez, L. Yeasts in fermented foods and their probiotic potential. Austin J. Nutr. Metab. 2017, 4, 1045. [Google Scholar]
- Moslehi-Jenabian, S.; Lindegaard, L.; Jespersen, L. Beneficial effects of probiotic and food borne yeasts on human health. Nutrients 2010, 2, 449–473. [Google Scholar] [CrossRef] [PubMed]
- Swangkeaw, J.; Vichitphan, S.; Butzke, C.E.; Vichitphan, K. Characterization of β-glucosidases from Hanseniaspora sp. and Pichia anomala with potentially aroma-enhancing capabilities in juice and wine. World J. Microbiol. Biotechnol. 2011, 27, 423–430. [Google Scholar] [CrossRef]
- Lee, S.-B.; Park, H.-D. Isolation and investigation of potential non-Saccharomyces yeasts to improve the volatile terpene compounds in Korean Muscat Bailey A wine. Microorganisms 2020, 8, 1552. [Google Scholar] [CrossRef] [PubMed]
- Zhang, W.; Zhuo, X.; Hu, L.; Zhang, X. Effects of crude β-glucosidases from Issatchenkia terricola, Pichia kudriavzevii, Metschnikowia pulcherrima on the flavor complexity and characteristics of wines. Microorganisms 2020, 8, 953. [Google Scholar] [CrossRef]
- Zhu, X.; Navarro, Y.; Mas, A.; Torija, M.-J.; Beltran, G. A rapid method for selecting non-Saccharomyces strains with a low ethanol yield. Microorganisms 2020, 8, 658. [Google Scholar] [CrossRef]
- Han, X.; Qing, X.; Yang, S.; Li, R.; Zhan, J.; You, Y.; Huang, W. Study on the diversity of non-Saccharomyces yeasts in Chinese wine regions and their potential in improving wine aroma by β-glucosidase activity analyses. Food Chem. 2021, 360, 129886. [Google Scholar] [CrossRef]
- Baschali, A.; Tsakalidou, E.; Kyriacou, A.; Karavasiloglou, N.; Matalas, A.-L. Traditional low-alcoholic and non-alcoholic fermented beverages consumed in European countries: A neglected food group. Nutr. Res. Rev. 2017, 30, 1–24. [Google Scholar] [CrossRef]
- Li, Y.; Zhang, S.; Sun, Y. Measurement of catechin and gallic acid in tea wine with HPLC. Saudi J. Biol. Sci. 2020, 27, 214–221. [Google Scholar] [CrossRef]
- Vasdev, S.; Gill, V.; Singal, P.K. Beneficial effect of low ethanol intake on the cardiovascular system: Possible biochemical mechanisms. Vasc. Health Risk Manag. 2006, 2, 263. [Google Scholar] [CrossRef]
- Helmy, E.; Soliman, S.; Abdel-Ghany, T.M.; Ganash, M. Evaluation of potentially probiotic attributes of certain dairy yeast isolated from buffalo sweetened Karish cheese. Heliyon 2019, 5, e01649. [Google Scholar] [CrossRef]
- Menezes, A.G.T.; Ramos, C.L.; Cenzi, G.; Melo, D.S.; Dias, D.R.; Schwan, R.F. Probiotic potential, antioxidant activity, and phytase production of indigenous yeasts isolated from indigenous fermented foods. Probiotics Antimicrob. Proteins 2020, 12, 280–288. [Google Scholar] [CrossRef]
- Amorim, J.C.; Piccoli, R.H.; Duarte, W.F. Probiotic potential of yeasts isolated from pineapple and their use in the elaboration of potentially functional fermented beverages. Food Res. Int. 2018, 107, 518–527. [Google Scholar] [CrossRef] [PubMed]
- Kurtzman, C.P.; Fell, J.W.; Boekhout, T.; Robert, V. Methods for isolation, phenotypic characterization and maintenance of yeasts. In The Yeasts; Elsevier: Amsterdam, The Netherlands, 2011; pp. 87–110. [Google Scholar]
- Suwannarach, N.; Kaewyana, C.; Yodmeeklin, A.; Kumla, J.; Matsui, K.; Lumyong, S. Evaluation of Muscodor cinnamomi as an egg biofumigant for the reduction of microorganisms on eggshell surfaces and its effect on egg quality. Int. J. Food Microbiol. 2017, 244, 52–61. [Google Scholar] [CrossRef] [PubMed]
- Wangkarn, S.; Grudpan, K.; Khanongnuch, C.; Pattananandecha, T.; Apichai, S.; Saenjum, C. Development of HPLC method for catechins and related compounds determination and standardization in Miang (Traditional Lanna fermented tea leaf in Northern Thailand). Molecules 2021, 26, 6052. [Google Scholar] [CrossRef] [PubMed]
- Abdullahi, A.D.; Kodchasee, P.; Unban, K.; Pattananandecha, T.; Saenjum, C.; Kanpiengjai, A.; Shetty, K.; Khanongnuch, C. Comparison of phenolic contents and scavenging activities of Miang extracts derived from filamentous and non-filamentous fungi-based fermentation processes. Antioxidants 2021, 10, 1144. [Google Scholar] [CrossRef]
- Canonico, L.; Zannini, E.; Ciani, M.; Comitini, F. Assessment of non-conventional yeasts with potential probiotic for protein-fortified craft beer production. LWT 2021, 145, 111361. [Google Scholar] [CrossRef]
- Fernández-Pacheco, P.; Rosa, I.Z.; Arévalo-Villena, M.; Gomes, E.; Pérez, A.B. Study of potential probiotic and biotechnological properties of non-Saccharomyces yeasts from fruit Brazilian ecosystems. Braz. J. Microbiol. 2021, 52, 2129–2144. [Google Scholar] [CrossRef]
- Senkarcinova, B.; Dias, I.A.G.; Nespor, J.; Branyik, T. Probiotic alcohol-free beer made with Saccharomyces cerevisiae var. boulardii. LWT 2019, 100, 362–367. [Google Scholar] [CrossRef]
- Tamang, J.P.; Lama, S. Probiotic properties of yeasts in traditional fermented foods and beverages. J. Appl. Microbiol. 2022, 132, 3533–3542. [Google Scholar] [CrossRef]
- Dalanezi, F.M.; da Paz, G.S.; Joaquim, S.F.; Guimarães, F.F.; Bosco, S.d.M.G.; Langoni, H. The first report of Cyberlindnera rhodanensis associated with clinical bovine mastitis. J. Dairy Sci. 2018, 101, 581–583. [Google Scholar] [CrossRef]
- World Health Organization; Food and Agriculture Organization of the United Nations; World Organisation for Animal Health. Monitoring Global Progress on Addressing Antimicrobial Resistance: Analysis Report of the Second Round of Results of AMR Country Self-Assessment Survey; WHO: Geneva, Switzerland, 2018; Volume 2018. [Google Scholar]
- Leangnim, N.; Aisara, J.; Unban, K.; Khanongnuch, C.; Kanpiengjai, A. Acid stable yeast cell-associated tannase with high capability in gallated catechin biotransformation. Microorganisms 2021, 9, 1418. [Google Scholar] [CrossRef] [PubMed]
- Huang, J.; Wang, Y.; Ren, Y.; Wang, X.; Li, H.; Liu, Z.; Yue, T.; Gao, Z. Effect of inoculation method on the quality and nutritional characteristics of low-alcohol kiwi wine. LWT 2022, 156, 113049. [Google Scholar] [CrossRef]
- Satora, P.; Tarko, T.; Sroka, P.; Blaszczyk, U. The influence of Wickerhamomyces anomalus killer yeast on the fermentation and chemical composition of apple wines. FEMS Yeast Res. 2014, 14, 729–740. [Google Scholar] [CrossRef] [PubMed]
- Wang, R.; Sun, J.; Lassabliere, B.; Yu, B.; Liu, S.Q. Biotransformation of green tea (Camellia sinensis) by wine yeast Saccharomyces cerevisiae. J. Food Sci. 2020, 85, 306–315. [Google Scholar] [CrossRef] [PubMed]
- Bellut, K.; Arendt, E.K. Chance and challenge: Non-Saccharomyces yeasts in nonalcoholic and low alcohol beer brewing–A review. J. Am. Soc. Brew. Chem. 2019, 77, 77–91. [Google Scholar] [CrossRef]
- Methner, Y.; Hutzler, M.; Zarnkow, M.; Prowald, A.; Endres, F.; Jacob, F. Investigation of non-Saccharomyces yeast strains for their suitability for the production of non-alcoholic beers with novel flavor profiles. J. Am. Soc. Brew. Chem. 2022, 80, 341–355. [Google Scholar] [CrossRef]
- Van Rijswijck, I.M.; van Mastrigt, O.; Pijffers, G.; Wolkers–Rooijackers, J.C.; Abee, T.; Zwietering, M.H.; Smid, E.J. Dynamic modelling of brewers’ yeast and Cyberlindnera fabianii co-culture behaviour for steering fermentation performance. Food Microbiol. 2019, 83, 113–121. [Google Scholar] [CrossRef]
- Longo, R.; Blackman, J.W.; Torley, P.J.; Rogiers, S.Y.; Schmidtke, L.M. Changes in volatile composition and sensory attributes of wines during alcohol content reduction. J. Sci. Food Agric. 2017, 97, 8–16. [Google Scholar] [CrossRef]
- Contreras, A.; Hidalgo, C.; Schmidt, S.; Henschke, P.; Curtin, C.; Varela, C. The application of non-Saccharomyces yeast in fermentations with limited aeration as a strategy for the production of wine with reduced alcohol content. Int. J. Food Microbiol. 2015, 205, 7–15. [Google Scholar] [CrossRef] [PubMed]
- Wang, C.; Mas, A.; Esteve-Zarzoso, B. The interaction between Saccharomyces cerevisiae and non-Saccharomyces yeast during alcoholic fermentation is species and strain specific. Front. Microbiol. 2016, 7, 502. [Google Scholar] [CrossRef]
- Wang, W.; Fan, G.; Li, X.; Fu, Z.; Liang, X.; Sun, B. Application of Wickerhamomyces anomalus in simulated solid-state fermentation for Baijiu production: Changes of microbial community structure and flavor metabolism. Front. Microbiol. 2020, 11, 598758. [Google Scholar] [CrossRef] [PubMed]
- Escalante, W.D.E. Perspectives and uses of non-Saccharomyces yeasts in fermented beverages. In Frontiers and New Trends in the Science of Fermented Food and Beverages; Books on Demand: Paris, France, 2019; p. 107. [Google Scholar]
- Vilela, A. Modulating wine pleasantness throughout wine-yeast co-inoculation or sequential inoculation. Fermentation 2020, 6, 22. [Google Scholar] [CrossRef]
- Methner, Y.; Hutzler, M.; Matoulková, D.; Jacob, F.; Michel, M. Screening for the brewing ability of different non-Saccharomyces yeasts. Fermentation 2019, 5, 101. [Google Scholar] [CrossRef]
- Xu, A.; Xiao, Y.; He, Z.; Liu, J.; Wang, Y.; Gao, B.; Chang, J.; Zhu, D. Use of non-Saccharomyces yeast co-fermentation with Saccharomyces cerevisiae to Improve the polyphenol and volatile aroma compound contents in Nanfeng Tangerine cines. J. Fungi 2022, 8, 128. [Google Scholar] [CrossRef] [PubMed]
- Unban, K.; Kodchasee, P.; Shetty, K.; Khanongnuch, C. Tannin-tolerant and extracellular tannase producing Bacillus isolated from traditional fermented tea leaves and their probiotic functional properties. Foods 2020, 9, 490. [Google Scholar] [CrossRef]
- Jayabalan, R.; Marimuthu, S.; Swaminathan, K. Changes in content of organic acids and tea polyphenols during kombucha tea fermentation. Food Chem. 2007, 102, 392–398. [Google Scholar] [CrossRef]
- Martínez Leal, J.; Valenzuela Suárez, L.; Jayabalan, R.; Huerta Oros, J.; Escalante-Aburto, A. A review on health benefits of kombucha nutritional compounds and metabolites. CyTA-J. Food 2018, 16, 390–399. [Google Scholar] [CrossRef]
- Chidi, B.S.; Bauer, F.; Rossouw, D. Organic acid metabolism and the impact of fermentation practices on wine acidity: A review. S. Afr. J. Enol. Vitic. 2018, 39, 1–15. [Google Scholar] [CrossRef]
- Wei, J.; Zhang, Y.; Yuan, Y.; Dai, L.; Yue, T. Characteristic fruit wine production via reciprocal selection of juice and non-Saccharomyces species. Food Microbiol. 2019, 79, 66–74. [Google Scholar] [CrossRef]
- Deshmukh, G.; Manyar, H. Production pathways of acetic acid and its versatile applications in the food industry. In Biomass; IntechOpen: London, UK, 2020. [Google Scholar]
- Li, Y.; Nguyen, T.T.H.; Jin, J.; Lim, J.; Lee, J.; Piao, M.; Mok, I.-K.; Kim, D. Brewing of glucuronic acid-enriched apple cider with enhanced antioxidant activities through the co-fermentation of yeast (Saccharomyces cerevisiae and Pichia kudriavzevii) and bacteria (Lactobacillus plantarum). Food Sci. Biotechnol. 2021, 30, 555–564. [Google Scholar] [CrossRef]
- Jayabalan, R.; Subathradevi, P.; Marimuthu, S.; Sathishkumar, M.; Swaminathan, K. Changes in free-radical scavenging ability of kombucha tea during fermentation. Food Chem. 2008, 109, 227–234. [Google Scholar] [CrossRef] [PubMed]
- Jakubczyk, K.; Kałduńska, J.; Kochman, J.; Janda, K. Chemical profile and antioxidant activity of the kombucha beverage derived from white, green, black and red tea. Antioxidants 2020, 9, 447. [Google Scholar] [CrossRef]
- Lai, Y.-T.; Hsieh, C.-W.; Lo, Y.-C.; Liou, B.-K.; Lin, H.-W.; Hou, C.-Y.; Cheng, K.-C. Isolation and identification of aroma-producing non-Saccharomyces yeast strains and the enological characteristic comparison in wine making. LWT 2022, 154, 112653. [Google Scholar] [CrossRef]
- Wang, R.; Sun, J.; Lassabliere, B.; Yu, B.; Liu, S.Q. β-Glucosidase activity of Cyberlindnera (Williopsis) saturnus var. mrakii NCYC 2251 and its fermentation effect on green tea aroma compounds. LWT 2021, 151, 112184. [Google Scholar] [CrossRef]
- Ho, C.-T.; Zheng, X.; Li, S. Tea aroma formation. Food Sci. Hum. Wellness 2015, 4, 9–27. [Google Scholar] [CrossRef]
- Yang, Z.; Baldermann, S.; Watanabe, N. Recent studies of the volatile compounds in tea. Food Res. Int. 2013, 53, 585–599. [Google Scholar] [CrossRef]
- Oliveira, I.; Ferreira, V. Modulating fermentative, varietal and aging aromas of wine using non-Saccharomyces yeasts in a sequential inoculation approach. Microorganisms 2019, 7, 164. [Google Scholar] [CrossRef]
- Dzialo, M.C.; Park, R.; Steensels, J.; Lievens, B.; Verstrepen, K.J. Physiology, ecology and industrial applications of aroma formation in yeast. FEMS Microbiol. Rev. 2017, 41, S95–S128. [Google Scholar] [CrossRef]
- Hazelwood, L.A.; Daran, J.-M.; Van Maris, A.J.; Pronk, J.T.; Dickinson, J.R. The Ehrlich pathway for fusel alcohol production: A century of research on Saccharomyces cerevisiae metabolism. Appl. Environ. Microbiol. 2008, 74, 2259–2266. [Google Scholar] [CrossRef]
- Walker, G.M.; Stewart, G.G. Saccharomyces cerevisiae in the production of fermented beverages. Beverages 2016, 2, 30. [Google Scholar] [CrossRef]
- Zha, M.; Sun, B.; Wu, Y.; Yin, S.; Wang, C. Improving flavor metabolism of Saccharomyces cerevisiae by mixed culture with Wickerhamomyces anomalus for Chinese Baijiu making. J. Biosci. Bioeng. 2018, 126, 189–195. [Google Scholar] [CrossRef] [PubMed]
- Jiang, Q.-x.; Li, L.-j.; Chen, F.; Rong, B.; Ni, H.; Zheng, F.-p. β-Glucosidase improve the aroma of the tea infusion made from a spray-dried Oolong tea instant. LWT 2022, 159, 113175. [Google Scholar] [CrossRef]
- Carpena, M.; Fraga-Corral, M.; Otero, P.; Nogueira, R.A.; Garcia-Oliveira, P.; Prieto, M.A.; Simal-Gandara, J. Secondary aroma: Influence of wine microorganisms in their aroma profile. Foods 2020, 10, 51. [Google Scholar] [CrossRef] [PubMed]
- Gutiérrez, A.; Boekhout, T.; Gojkovic, Z.; Katz, M. Evaluation of non-Saccharomyces yeasts in the fermentation of wine, beer and cider for the development of new beverages. J. Inst. Brew. 2018, 124, 389–402. [Google Scholar] [CrossRef]
- Aung, M.T.; Lee, P.-R.; Yu, B.; Liu, S.-Q. Cider fermentation with three Williopsis saturnus yeast strains and volatile changes. Ann. Microbiol. 2015, 65, 921–928. [Google Scholar] [CrossRef]
- Ravasio, D.; Carlin, S.; Boekhout, T.; Groenewald, M.; Vrhovsek, U.; Walther, A.; Wendland, J. Adding flavor to beverages with non-conventional yeasts. Fermentation 2018, 4, 15. [Google Scholar] [CrossRef]
- Bellut, K.; Michel, M.; Zarnkow, M.; Hutzler, M.; Jacob, F.; De Schutter, D.P.; Daenen, L.; Lynch, K.M.; Zannini, E.; Arendt, E.K. Application of non-Saccharomyces yeasts isolated from kombucha in the production of alcohol-free beer. Fermentation 2018, 4, 66. [Google Scholar] [CrossRef]
- Liu, S.-Q.; Quek, A.Y.H. Evaluation of beer fermentation with a novel yeast Williopsis saturnus. Food Technol. Biotechnol. 2016, 54, 403. [Google Scholar] [CrossRef]
- López, M.C.; Mateo, J.J.; Maicas, S. Screening of β-glucosidase and β-xylosidase activities in four non-Saccharomyces yeast isolates. J. Food Sci. 2015, 80, C1696–C1704. [Google Scholar] [CrossRef]

| Isolate | Survival Rate (%) | Microbial Adhesion to Solvents (%) | ||
|---|---|---|---|---|
| Bile Salt | pH2 | pH3 | ||
| W. anomalus P2 | 91.42 ± 0.10 a | 91.76 ± 0.18 b | 96.40 ± 0.08 b | 43.81 ± 0.89 c |
| C. rhodanensis P3 | 70.28 ± 0.81 d | 83.88 ± 0.15 c | 99.71 ± 0.09 a | 39.45 ± 0.54 d |
| W. anomalus P7 | 66.61 ± 0.68 e | 84.67 ± 0.11 c | 99.94 ± 0.08 a | 31.14 ± 0.62 e |
| C. rhodanensis P9 | 75.51 ± 0.12 c | 91.86 ± 0.23 b | 95.21 ± 0.12 b | 52.31 ± 0.94 b |
| S. cerevisiae TISTR 5088 | 85.59 ± 0.66 b | 95.93 ± 0.01 a | 99.61 ± 0.01 a | 63.77 ± 1.02 a |
| Characteristic | Strains | Characteristic | Strains | ||||||
|---|---|---|---|---|---|---|---|---|---|
| P2 | P3 | P7 | P9 | P2 | P3 | P7 | P9 | ||
| Assimilation of Carbon | Assimilation of Carbon | ||||||||
| D-galactose | + | - | - | + | Potassium gluconate | - | w | w | - |
| Cyacloheximide (actidione) | - | - | - | - | Levulinic acid | - | - | - | - |
| D-saccharose (sucrose) | + | + | + | + | D-Glucose | + | + | + | + |
| N-Acetyl-glucosamine | + | - | - | + | L-Sorbose | - | w | w | - |
| Lactic acid | + | + | + | + | Glucosamine | - | - | - | - |
| L-arabinose | - | - | - | - | Esculin | + | + | + | + |
| D-Cellobiose | - | + | + | - | Fermentation | ||||
| D-Raffinose | + | - | - | + | Cellobiose | - | + | + | - |
| D-Maltose | + | + | + | + | D-glucose | + | + | + | + |
| D-Trehalose | - | + | + | - | D-galactose | + | - | - | + |
| Potassium 2 ketogluconate | - | - | - | - | Maltose | + | w | w | + |
| Methyl-αD-glucopyranoside | + | - | - | + | Sucrose | + | + | + | + |
| D-Mannitol | + | - | - | + | Lactose | - | - | - | - |
| D-Lactose (bovine origin) | + | - | - | + | Trehalose | - | - | - | - |
| Inositol | - | - | - | - | Raffinose | + | - | - | + |
| D-Sorbitol | + | + | + | + | Xylose | - | + | + | - |
| D-Xylose | + | + | + | + | Other Growth Characteristics | ||||
| D-Ribose | + | - | - | + | 50% glucose yeast extract | + | + | + | + |
| Glycerol | + | + | + | + | 60% glucose yeast extract | + | + | + | + |
| L-Rhamnose | - | + | + | - | 10% NaCl | - | - | - | - |
| Palatinose | + | + | + | + | Growth at 20 °C | + | + | + | + |
| Erythritol | + | - | - | + | Growth at 25 °C | + | + | + | + |
| D-Melibiose | - | - | - | - | Growth at 30 °C | + | + | + | + |
| Sodium glucuronate | - | - | - | - | Growth at 37 °C | + | + | + | + |
| D-Melezitose | + | + | + | + | Growth at 45 °C | - | - | - | - |
| Property | Miang Broth Original | Control (0 h) | Following 120 h Fermentation | |||||||
|---|---|---|---|---|---|---|---|---|---|---|
| Control | 5088 | P2 | P3 | 5088 + P2 | 5088 + P3 | P2 + P3 | 5088 + P2 + P3 | |||
| Glucose (g/L) | 3.56 ± 0.02 | 53.21 ± 0.02 h | 53.27 ± 0.12 h | 0.19 ± 0.01 b | 23.86 ± 0.45 e | 33.19 ± 0.32 f | 7.93 ± 0.12 c | 9.50 ± 0.21 d | 46.20 ± 1.09 g | 0.00 ± 0.00 a |
| Ethanol (g/L) | 0.00 ± 0.00 f | 0.00 ± 0.00 f | 0.00 ± 0.00 f | 23.67 ± 0.70 b | 11.03 ± 0.07 d | 11.56 ± 0.00 d | 20.74 ± 0.0 c | 20.15 ± 0.50 c | 2.93 ± 0.0 e | 24.91 ± 0.0 a |
| pH | 4.06 ± 0.0 a | 4.1 ± 0.0 a | 4.08 ± 0.03 a | 3.9 ± 0.04 a | 3.94 ± 0.00 a | 4.04 ± 0.06 a | 3.91 ± 0.03 a | 3.97 ± 0.0 a | 4.02 ± 0.02 a | 4.02 ± 0.0 a |
| Organic acid | ||||||||||
| Acetic acid (g/L) | 3.04 ± 0.15 a | 2.24 ± 0.12 d | 1.91 ± 001 f | 1.37 ± 0.15 f | 2.03 ± 0.12 e | 1.72 ± 0.02 f | 3.09 ± 0.34 a | 2.64 ± 0.25 b | 1.48 ± 0.12 g | 2.42 ± 0.18 d |
| Citric acid (g/L) | 2.79 ± 0.05 a | 1.17 ± 0.09 de | 1.22 ± 0.2 de | 1.21 ± 0.05 de | 1.16 ± 0.05 f | 0.93 ± 0.01 f | 1.47 ± 0.01 b | 1.17 ± 0.02 de | 1.28 ± 0.03 cd | 1.38 ± 0.02 bc |
| Glucuronic acid (g/L) | 1.70 ± 0.15 b | 1.20 ± 0.01 e | 1.31 ± 0.2 de | 1.39 ± 0.03 d | 2.02 ± 0.23 a | 1.57 ± 0.04 c | 2.04 ± 0.04 a | 1.75 ± 0.02 b | 1.29 ± 0.01 de | 1.94 ± 0.01 a |
| Lactic acid (g/L) | 1.90 ± 0.01 a | 1.10 ± 0.03 d | 1.08 ± 0.05 d | 1.38 ± 0.03 bc | 1.31 ± 0.01 c | 1.08 ± 0.02 d | 1.44 ± 0.05 b | 1.31 ± 0.01 bc | 1.37 ± 0.03 bc | 1.45 ± 0.03 b |
| Oxalic acid (g/L) | 0.22 ± 0.02 a | 0.13 ± 0.02 bc | 0.13 ± 0.01 bc | 0.15 ± 0.01 bc | 0.17 ± 0.04 ab | 0.10 ± 0.01 c | 0.16 ± 0.01 bc | 0.13 ± 0.03 bc | 0.15 ± 0.01 bc | 0.14 ± 0.01 bc |
| Succinic acid (g/L) | 2.59 ± 0.06 a | 1.61 ± 0.05 de | 1.81 ± 0.14 c | 1.08 ± 0.07 g | 1.45 ± 0.01 f | 1.19 ± 0.01 g | 1.65 ± 0.04 de | 1.55 ± -0.05 ef | 1.76 ± 0.05 cd | 2.02 ± 0.01 b |
| Bioactive compounds | ||||||||||
| Total polyphenol (g/L) | 7.86 ± 0.2 a | 7.70 ± 0.98 a | 6.61 ± 0.28 b | 7.97 ± 0.09 a | 8.15 ± 0.015 a | 7.98 ± 0.06 a | 7.99 ± 0.12 a | 8.27 ± 0.31 a | 7.24 ± 0.02 b | 6.54 ± 0.07 b |
| Total tannin (g/L) | 6.26 ± 0.0 b | 6.73 ± 0.21 ab | 6.09 ± 0.35 b | 7.07 ± 0.28 ab | 6.96 ± 0.09 ab | 7.12 ± 0.15 ab | 7.71 ± 0.06 a | 7.91 ± 0.12 a | 6.94 ± 0.31 ab | 6.00 ± 0.02 ab |
| Total flavonoid (g/L) | 0.30 ± 0.01 a | 0.27 ± 0.09 a | 0.26 ± 0.23 a | 0.36 ± 0.08 a | 0.37 ± 0.13 a | 0.37 ± 0.07 a | 0.23 ± 0.01 a | 0.20 ± 0.02 a | 0.20 ± 0.03 a | 0.24 ± 0.01 a |
| DPPH free radical scavenging (%) | 67.91 ± 0.06 a | 66.15 ± 2.69 a | 67.28 ± 0.90 a | 68.93 ± 1.47 a | 71.38 ± 1.22 a | 69.69 ± 2.35 a | 70.23 ± 3.78 a | 71.43 ± 1.70 a | 69.49 ± 1.60 a | 70.23 ± 1.13 a |
| Total catechin (g/L) | 2.22 ± 0.01 a | 1.4 ± 0.02 d | 1.24 ± 0.01 e | 1.22 ± 0.01 e | 1.23 ± 0.01 e | 1.64 ± 0.00 b | 1.43 ± 0.00 d | 1.53 ± 0.01 d | 1.64 ± 0.00 b | 1.60 ± 0.01 b |
| Catechin (g/L) | 1.02 ± 0.01 a | 0.53 ± 0.02 f | 0.51 ± 0.01 f | 0.56 ± 0.03 e | 0.56 ± 0.03 e | 0.77 ± 0.02 b | 0.66 ± 0.03 d | 0.71 ± 0.12 c | 0.75 ± 0.03 b | 0.71 ± 0.02 c |
| Gallocatechin (g/L) | 0.74 ± 0.03 a | 0.44 ± 0.03 b | 0.35 ± 0.02 c | 0.25 ± 0.03 e | 0.24 ± 0.04 e | 0.33 ± 0.03 c | 0.26 ± 0.01 e | 0.26 ± 0.03 e | 0.30 ± 0.01 d | 0.30 ± 0.00 d |
| Epigallocatechin (g/L) | 0.13 ± 0.01 f | 0.17 ± 0.00 f | 0.13 ± 0.01 f | 0.15 ± 0.01 e | 0.16 ± 0.00 de | 0.20 ± 0.01 c | 0.19 ± 0.01 c | 0.21 ± 0.01 b | 0.21 ± 0.02 b | 0.26 ± 0.01 a |
| Epicatechin (g/L) | 0.15 ± 0.01 d | 0.20 ± 0.00 c | 0.20 ± 0.01 c | 0.21 ± 0.01 c | 0.21 ± 0.01 c | 0.26 ± 0.01 b | 0.24 ± 0.01 b | 0.25 ± 0.01 b | 0.29 ± 0.01 a | 0.24 ± 0.01 b |
| Epigallocatechin gallate (g/L) | 0.18 ± 0.01 a | 0.06 ± 0.001 de | 0.05 ± 0.00 e | 0.05 ± 0.00 e | 0.06 ± 0.01 de | 0.08 ± 0.00 cd | 0.08 ± 0.02 bc | 0.10 ± 0.02 b | 0.09 ± 0.01 bc | 0.09 ± 0.00 bc |
| Gallic acid (g/L) | 0.13 ± 0.01 a | 0.05 ± 0.01 b | 0.05 ± 0.01 b | 0.06 ± 0.01 b | 0.06 ± 0.01 b | 0.06 ± 0.00 b | 0.05 ± 0.00 b | 0.06 ± 0.00 b | 0.06 ± 0.00 b | 0.06 ± 0.00 b |
| Pyrogallol (g/L) | 0.55 ± 0.01 a | 0.32 ± 0.01 c | 0.42 ± 0.01 b | 0.33 ± 0.02 c | 0.31 ± 0.01 de | 0.32 ± 0.02 cd | 0.29 ± 0.02 de | 0.28 ± 0.01 e | 0.31 ± 0.01 cd | 0.32 ± 0.01 cd |
| Caffeine (g/L) | 0.86 ± 0.02 a | 0.55 ± 0.02 ef | 0.58 ± 0.02 cd | 0.59 ± 0.01 bc | 0.58 ± 0.02 cd | 0.61 ± 0.02 b | 0.53 ± 0.01 f | 0.58 ± 0.02 cd | 0.57 ± 0.02 cd | 0.55 ± 0.03 de |
Disclaimer/Publisher’s Note: The statements, opinions and data contained in all publications are solely those of the individual author(s) and contributor(s) and not of MDPI and/or the editor(s). MDPI and/or the editor(s) disclaim responsibility for any injury to people or property resulting from any ideas, methods, instructions or products referred to in the content. |
© 2023 by the authors. Licensee MDPI, Basel, Switzerland. This article is an open access article distributed under the terms and conditions of the Creative Commons Attribution (CC BY) license (https://creativecommons.org/licenses/by/4.0/).
Share and Cite
Kodchasee, P.; Pharin, N.; Suwannarach, N.; Unban, K.; Saenjum, C.; Kanpiengjai, A.; Sakar, D.; Shetty, K.; Zarnkow, M.; Khanongnuch, C. Assessment of Tannin Tolerant Non-Saccharomyces Yeasts Isolated from Miang for Production of Health-Targeted Beverage Using Miang Processing Byproducts. J. Fungi 2023, 9, 165. https://doi.org/10.3390/jof9020165
Kodchasee P, Pharin N, Suwannarach N, Unban K, Saenjum C, Kanpiengjai A, Sakar D, Shetty K, Zarnkow M, Khanongnuch C. Assessment of Tannin Tolerant Non-Saccharomyces Yeasts Isolated from Miang for Production of Health-Targeted Beverage Using Miang Processing Byproducts. Journal of Fungi. 2023; 9(2):165. https://doi.org/10.3390/jof9020165
Chicago/Turabian StyleKodchasee, Pratthana, Nattanicha Pharin, Nakarin Suwannarach, Kridsada Unban, Chalermpong Saenjum, Apinun Kanpiengjai, Dipayan Sakar, Kalidas Shetty, Martin Zarnkow, and Chartchai Khanongnuch. 2023. "Assessment of Tannin Tolerant Non-Saccharomyces Yeasts Isolated from Miang for Production of Health-Targeted Beverage Using Miang Processing Byproducts" Journal of Fungi 9, no. 2: 165. https://doi.org/10.3390/jof9020165
APA StyleKodchasee, P., Pharin, N., Suwannarach, N., Unban, K., Saenjum, C., Kanpiengjai, A., Sakar, D., Shetty, K., Zarnkow, M., & Khanongnuch, C. (2023). Assessment of Tannin Tolerant Non-Saccharomyces Yeasts Isolated from Miang for Production of Health-Targeted Beverage Using Miang Processing Byproducts. Journal of Fungi, 9(2), 165. https://doi.org/10.3390/jof9020165

